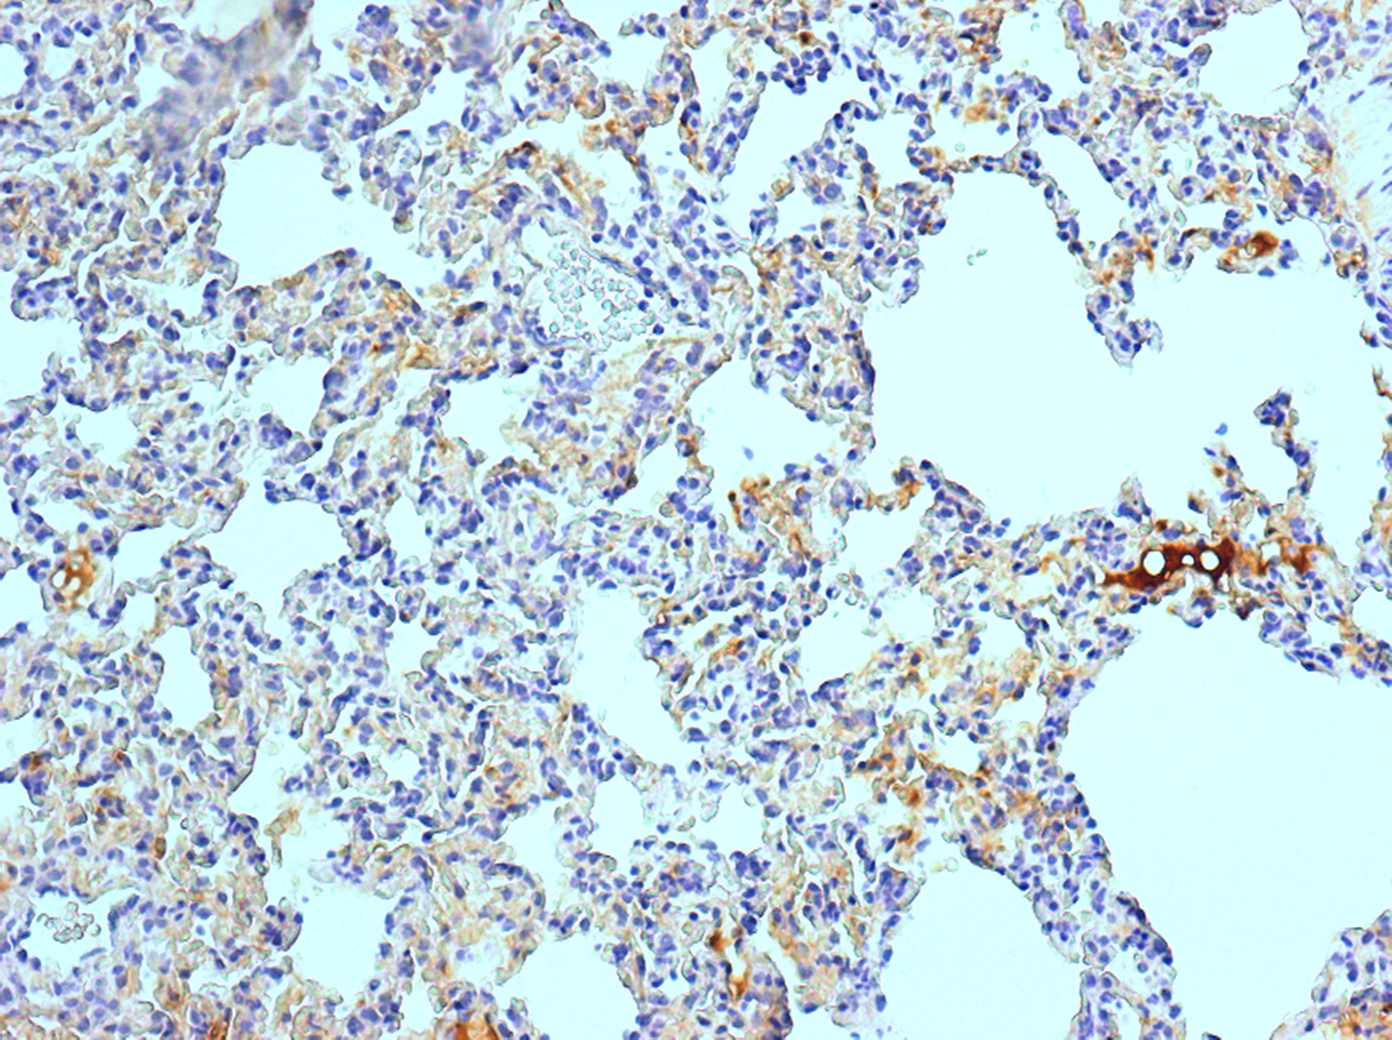

Product No: MAB894P
Source/Host: Mouse
Unit: 7 ml
CD68 (Macrophage) antibody – Ready To Use
Product No: MAB894P
Source/Host: Mouse
Unit: 7 ml
$515.00
SKU
MAB894P
Category Primary Antibodies (Validated for IHC & ICC)
Product categories
- Primary Antibodies (Validated for IHC & ICC)
- Universal Fc Receptors Blocker
- Background Buster (BB) Ready-To-Use
- STAT-Q IHC Staining Kits & kit Components (Background-free)
- Universal Animal IHC/ICC Kit
- 1-Step Polymer HISTO-STAT Kits & kit Components (Background free)
- UNI-TRIEVE 37-75 Degree Water Bath Retrieval
- IHC Enhancing Wash Buffers
- DAB, AEC, Black DAB & Fast Red Stable Chromogens/Substrates
- DAB, AEC, & Fast Red Enchancers
- Mounting Media (Permanent)
- HIER Retrieval Solution with pH Stabilizer
- Double Staining Products
- Hematoxylin & Nuclear Red & CytoBlue Counterstains
- Multi-Tumor Control Slides
- Negative Control Sera, validated for IHC & ICC
- Isotype Controls, validated for IHC & ICC
- Cyto Q Immuno Diluent & Block
- IHC Wash Buffers
- PEROX-BLOCK